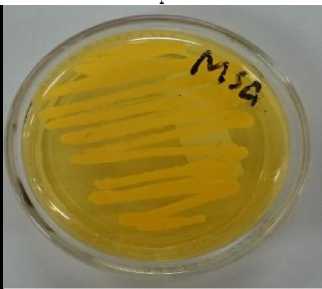
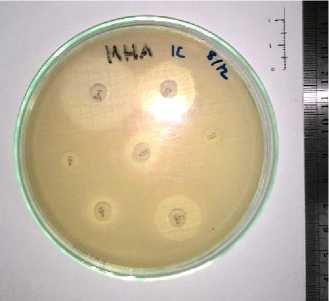

MULTIDRUG-RESISTANT STAPHYLOCOCCUS AUREUS ISOLATED FROM CATTLE MILK IN INDONESIA
on
Volume 15 No. 2: 325-331
April 2023
DOI: 10.24843/bulvet.2023.v15.i02.p20
Buletin Veteriner Udayana
pISSN: 2085-2495; eISSN: 2477-2712
Online pada: http://ojs.unud.ac.id/index.php/buletinvet
Terakreditasi Nasional Sinta 4, berdasarkan Keputusan Direktur Jenderal
Pendidikan Tinggi, Riset, dan Teknologi No. 158/E/KPT/2021
Multidrug-Resistant Staphylococcus aureus Isolated from Cattle Milk in Indonesia
(STAPHYLOCOCCUS AUREUS RESISTAN TERHADAP BERBAGAI ANTIMIKROBA YANG DIISOLASI DARI SUSU SAPI DI INDONESIA)
Dordia Anindita Rotinsulu1*, Usamah Afiff1, Chairani Ridha Maghfira2 1Division of Medical Microbiology, School of Veterinary Medicine and Biomedical Sciences, IPB University, Jl. Agatis Kampus IPB Darmaga Bogor, Indonesia, 16680; 2Student of School of Veterinary Medicine and Biomedical Sciences, IPB University, Jl.
Agatis Kampus IPB Darmaga Bogor, Indonesia, 16680.
*Email: dordia.rotinsulu@apps.ipb.ac.id
Abstract
Staphylococcus aureus (S. aureus) is one of the common causes of bovine mastitis worldwide. Inappropriate use of antimicrobials in cattle farms contributes to the increase of the antimicrobial resistance of S. aureus. This study aimed to investigate the antimicrobial resistance profiles of S. aureus isolated from cattle milk. Twelve S. aureus isolated from cattle milk in Bogor, Indonesia, were tested against seven antimicrobials using Kirby-Bauer disk diffusion susceptibility test. The results revealed that 58.3 % of isolates were multidrug-resistant S. aureus. The S. aureus isolates were resistant to penicillin G (66.7 %), ampicillin (66.7 %), vancomycin (58.3 %), and bacitracin (58.3 %). Most of the isolates were susceptible to ciprofloxacin (91.7 %), gentamicin (66.7 %), and chloramphenicol (66.67 %). If clinically indicated, treatment of mastitis should consider the antimicrobial susceptibility of the causative agent.
Keywords: Staphylococcus aureus; antimicrobials; resistance; bovine mastitis
Abstrak
Staphylococcus aureus (S. aureus) merupakan salah satu penyebab utama mastitis pada sapi di seluruh dunia. Penggunaan antimikroba secara tidak tepat di peternakan sapi menyebabkan peningkatan bakteri yang resistan terhadap antimikroba. Penelitian ini bertujuan untuk menginvestigasi profil resistansi antimikroba S. aureus yang diisolasi dari susu sapi. Dua belas isolat S. aureus yang diisiolasi dari sampel susu sapi di Bogor, Indonesia, diuji terhadap tujuh antimikroba menggunakan metode agar difusi menurut Kirby-Bauer. Hasil penelitian menunjukkan bahwa 58.3 % isolat merupakan S. aureus resistan terhadap beberapa antimikroba. Isolat S. aureus yang diuji resistan terhadap penisilin G (66,7 %), ampisilin (66,7 %), vankomisin (58,3 %), dan basitrasin (58,3 %). Sebagian besar isolat sensitif terhadap siprofloksasin (91,7 %), gentamisin (66,7 %), dan kloramfenikol (66,67 %). Pengobatan mastitis harus mempertimbangkan resistansi antimikroba dari bakteri penyebab penyakit.
Kata kunci: Staphylococcus aureus; antimikroba; resistan; mastitis
INTRODUCTION
Bovine mastitis is one of the most common diseases affecting the quantity and quality of world milk production (Ruegg, 2017; Wang et al., 2022). Mastitis incurs various costs, including decreased milk production, condemnation of milk due to antibiotic residues, veterinary expenses, and culling of chronically infected cattle (Nurhayati and Martindah, 2015; Abebe et
al., 2016). Staphylococcus aureus (S. aureus), a Gram-positive bacterium, is one of the common causes of bovine mastitis worldwide (Ruegg, 2017, Abebe et al., 2016; Chaalal et al., 2016).
A previous study reported that the treatment of subclinical and clinical mastitis in Indonesia is still not effective because it generally uses broad-spectrum antimicrobials without conducting a specific analysis of the causative agent
(Nurhayati and Martindah, 2015). Antimicrobials often used in farms include penicillin, tetracycline, aminoglycosides, and macrolides (Meutia et al., 2016). Inappropriate use of antimicrobials causes antimicrobial resistance, which is now a global problem. Previous studies reported that antimicrobial-resistant bacteria were isolated from cattle in Indonesia (Klobongona et al., 2019; Tyasningsih et al., 2021; Rotinsulu et al., 2022). In order to maximise the benefits of antimicrobial stewardship, continuous monitoring of bacterial pathogens for antimicrobial resistance is essential. The use of antimicrobials to treat bacterial infections caused by S. aureus in cattle farms encourages the investigation of antimicrobial resistance of S. aureus isolated from cattle milk.
This study aimed to investigate the antimicrobial resistance patterns of S. aureus isolated from cattle milk against penicillin G, ampicillin, vancomycin, gentamicin, bacitracin, ciprofloxacin, and chloramphenicol. Furthermore, the results of this study can help clinicians in selecting appropriate antimicrobials for treating mastitis caused by S. aureus.
RESEARCH METHODS
Materials and Equipment
Materials used in this study were twelve S. aureus isolates, crystal violet, lugol’s iodine, safranin, H2O2 3%, glucose fermentation test, 0.5 McFarland standard, blood agar, tryptic soy agar (TSA), mannitol salt agar (MSA), Mueller-Hinton agar (MHA), antimicrobial discs penicillin G (10 IU), ampicillin (10 μg), vancomycin (30 μg), gentamicin (10 μg), bacitracin (10 IU), ciprofloxacin (5 μg), and chloramphenicol (30 μg). Equipment used in this study were anaerobic jar, sterile cotton swab, inoculation needle (öse), forceps, bunsen burner, vortex mixer, 37 oC aerobe incubator, sterile cabinet, refrigerator, and ruler.
Identification of Staphylococcus aureus
Isolates used in this study were twelve S. aureus isolates from the bacterial culture collection of the Laboratory of Bacteriology, Division of Medical Microbiology, School of Veterinary Medicine and Biomedical Sciences, IPB University, Bogor, Indonesia. All S. aureus were isolated from raw milk of cattle that had mastitis in Bogor, Indonesia. All isolates were re-assessed for species identification using standard bacterial culture procedure (Carter and Cole 1990; FDA 2005). Briefly, tested bacterial cultures were inoculated on blood agar plates and then incubated aerobically for 24 hours at 37 oC. Agar plates were examined for colony morphologic features, including colony shape, size, colour, and haemolytic characteristics. Single colonies with macroscopic phenotype suspected as Staphlycoccocci were subcultured on TSA and incubated for 24 hours at 37 oC. Further identification was performed using Gram staining and biochemical reactions. Only Gram-positive cocci bacteria arranged in clusters were included for the further biochemical test, consisting of catalase test, glucose fermentation test in
microaerophilic condition, colony
morphology on manitol salt agar, and coagulase test (Carter and Cole 1990; FDA 2005).
Antimicrobial Susceptibility Test
The antimicrobial resistance test of S. aureus was conducted using the Kirby-Bauer disk diffusion susceptibility test protocol according to Clinic Laboratory Standard Institute (CLSI 2020). Bacterial suspension equal to 0.5 McFarland standard was inoculated on MHA using a sterile cotton swab over the entire agar surface. Afterwards, seven antimicrobial discs with known concentrations (penicillin G, ampicillin, vancomycin, gentamicin, bacitracin, ciprofloxacin, and
chloramphenicol) were placed on the MHA plate using sterile forceps. Agar plates were incubated aerobically at 37 oC for 24 hours. The antimicrobial susceptibility test was
performed in triplicates for each isolate. Interpretation of susceptible (S), intermediate (I), dan resistant (R) was conducted based on the size of the inhibition zone according to the breakpoints recommended by Clinical and Laboratory Standards Institute (CLSI 2020).
Data Analysis and Interpretation
Data were processed using Microsoft Excel 2016. Results were analyzed descriptively and visualised using tables and figures.
RESULTS AND DISCUSSION
Results
All twelve isolates were confirmed as S. aureus based on their macroscopic phenotype on the agar plate, microscopic morphology, and biochemical properties. All isolates formed double zone haemolysis on blood agar plates (Figure 1), were Grampositive cocci in clusters, catalase positive, glucose positive, coagulase positive, and had yellow colonies on MSA (Figure 2).
The antimicrobial susceptibility test was conducted against seven antimicrobials belonging to various antimicrobials classes, namely penicillin G (beta-lactams), ampicillin (beta-lactams), vancomycin (glycopeptides), gentamicin (aminoglycosides), bacitracin (polypeptides), ciprofloxacin (fluoroquinolones), and chloramphenicol (phenicols) (Figure 3).
The antimicrobial susceptibility test revealed that the tested S. aureus isolates had various antimicrobial resistance patterns. Seven isolates (58.3 %) were multidrug-resistant S. aureus. Interestingly, one isolate (SA08) was resistant to all tested antimicrobials, while another isolate (SA04) was susceptible to all tested antimicrobials (Table 1). Most isolates were resistant to penicillin G (66.7 %), ampicillin (66.7 %), vancomycin (58.3 %), and bacitracin (58.3 %). Almost all isolates were susceptible to ciprofloxacin (91.7 %), and more than half of the isolates were
susceptible to gentamicin (66.7 %), and chloramphenicol (66.7 %) (Figure 4).
Discussion
Most of the isolates were resistant to the two tested beta-lactam antimicrobials, namely penicillin G and ampicillin. These results correlate with studies of bovine mastitis in Asia where 77.3 % S. aureus in China were resistant to penicillin G and ampicillin (Li et al., 2009), and 66 % S. aureus in Korea were resistant to penicillin (Nam et al., 2011). Additionally, 35.4 % and 15.1% of dairy cattle herds in Canada had antimicrobial-resistant S. aureus against penicillin G and ampicillin, respectively (Saini et al., 2012). Both antimicrobials were previously commonly used to treat bacterial infections in cattle (Li et al., 2009). However, the increase of S. aureus resistance against beta-lactams antimicrobials argues against their use in cattle with mastitis caused by S. aureus.
Methicillin is one important antimicrobial belonging to the betalactamase antimicrobial class (CLSI 2020). Methicillin-resistant S. aureus (MRSA) strain is resistant to most beta-lactam antimicrobials, which makes the treatment challenging (Fessler et al., 2010; Khairullah et al., 2020). MRSA associated with bovine mastitis was first described in 1975 (Devriese and Hommez, 1975). Currently, MRSA has been reported worldwide (Fessler et al., 2010; Nam et al., 2011; Khairullah et al., 2020). It would be interesting to investigate the antimicrobial susceptibility of the S. aureus isolates in this study against methicilin.
More than half (58.3 %) of the S. aureus isolates in this study were resistant against vancomycin. Vancomycin resistance was also reported by Sashidaran et al., (2011) in Malaysia and Daka et al., (2012) in Ethopia. In Ethiopia, 23.5 – 70 % of S. aureus isolates from cattle milk were resistant to vancomycin (Daka et al., 2012). Furthermore, over half (58.3 %) of S. aureus isolates in this study were resistant to bacitracin. A study in Algeria reported that 70 % of methicillin susceptible S.
aureus isolated from milk were resistant to bacitracin (Chaalal et al., 2016).
In this study, most isolates were susceptible to ciprofloxacin, gentamicin, and chloramphenicol. These results correlate with a meta-analysis of bovine-associated S. aureus in China which reported that 63.8 %, 73.6 %, and 89.7 % S. aureus isolates were susceptible to quinolones, aminoglycosides, and
phenicols, respectively (Wang et al., 2022). A study in Korea showed that 88.1 % S. aureus isolates were susceptible to gentamicin (Nam et al., 2011), while another study in Germany reported that 68.7 % MRSA isolates were susceptible to gentamicin (Fessler et al., 2010). In
Uganda, Staphylococci isolated from bovine mastitis cases were susceptible to ciprofloxacin and gentamicin (Kateete et al., 2013). This result implies that these antimicrobials are still effective in treating bovine mastitis caused by S. aureus. However, antimicrobial stewardship should be considered in applying these drugs, especially for chloramphenicol which is a broad-spectrum antimicrobial.
CONCLUSION AND RECOMMENDATION
Conclusion
This study revealed that multidrugresistant S. aureus isolates were isolated from cattle milk in Bogor Regency, Indonesia. These isolates were resistant to penicillin G (66.7 %), ampicillin (66.7 %), vancomycin (58.3 %), and bacitracin (58.3 %). However, most of the isolates were still susceptible to ciprofloxacin (91.7 %), gentamicin (66.7 %), and chloramphenicol (66.67 %). If clinically indicated, treatment of mastitis should consider the antimicrobial susceptibility of the causative agent.
Recommendation
Further study is necessary to determine antimicrobial-resistant S. aureus isolated from more samples and a wider area. Moreover, antimicrobial resistance genes
should be determined, especially for multidrug-resistant strains.
ACKNOWLEDGEMENT
The author would like to thank Agus Sumantri and Ismet, IPB University, for their technical assistance.
REFERENCES
Abebe R, Hatiya H, Abera M, Bekele Megersa B, Asmare K. 2016. Bovine mastitis: prevalence, risk factors and isolation of Staphylococcus aureus in dairy herds at Hawassa milk shed, South Ethiopia. BMC Vet. Res. 12(270): 1-12.
Carter GR, Cole JR. 1990. Diagnostic Procedures in Veterinary Bacteriology and Mycology. San Diego (US): Academic Press. Inc.
Chaalal W, Aggad W, Zidane K, Saidi N, Kihal M. 2016. Antimicrobial susceptibility profiling of
Staphylococcus aureus isolates from milk. Braz. Microbiol. Res. J. 13(3): 17.
[CLSI]. Clinical and Laboratory Standards Institute. 2020. Performance standards for antimicrobial disk and dilution susceptibility test for bacteria isolated from animals. 5th ed. CLSI supplement VET01S. The USA.
Daka D, Silassie SG, Yihdego D. 2012. Antibiotic-resistance Staphylococcus aureus isolated from cow’s milk in the Hawassa area, South Ethiopia. Ann. Clin. Microbiol. Antimicrob. 11(26): 16.
Devriese LA, Hommez J. 1975. Epidemiology of methicillin-resistant Staphylococcus aureus in dairy herds. Res. Vet. Sci. 19: 23 -7
[FDA] Food and Drug Administration. 2005. Isolation and identification of Staphylococcus aureus in foods. In Bacteriological analytical manual 8th ed. Gaithersbug: AOAC International.
Fessler A, Scott C, Kadlec K, Ehricht R, Monecke S, Schwarz S. 2010.
Characterization of methicillin-resistant Staphylococcus aureus ST398 from cases of bovine mastitis. J. Antimicrob. Chem. 65(4): 619-625.
Kateete DP, Kabugo U, Baluku H, Nyakarahuka L, Kyobe S, Okee M, Najjuka CF, Joloba ML. 2013. Prevalence and antimicrobial
susceptibility patterns of bacteria from milkmen and cows with clinical mastitis in and around Kampala, Uganda. PlosOne. 8(5): 1-12.
Khairullah AR, Ramandinianto SC, Effendi MH. 2020. A Review of Livestock-Associated Methicillin-Resistant
Staphylococcus aureus (LA-MRSA) on Bovine Mastitis. Sys. Rev. Pharm. 11(7): 172-183.
Klobongona MLMNB, Afiff U, Rotinsulu DA. 2019. Efektivitas antimikroba terhadap Pasteurella multocida dan Mannheimia haemolityca dari sapi yang diduga menderita bovine respiratory disease kompleks. ARSHI Vet. Lett. 3(2): 39-40.
Li JP, Zhou HJ, Yuan L, He T, Hu SH. 2009. Prevalence, genetic diversity, and antimicrobial susceptibility profiles of Staphylococcus aureus isolated from bovine mastitis in Zhejiang Province, China. J. Zhejiang Univ. Sci. B. 10(10): 753-760.
Meutia N, Rizalsyah, Saiful R, Mitha KS. 2016. Residu antibiotik dalam air susu segar yang berasal dari peternakan di wilayah Aceh Besar. JITV. 16(1): 1-5.
Nam HM, Lee AL, Jung SC, Kim MN, Jang GC, Wee SH, Lim SK. 2011. Antimicrobial susceptibility of
Staphylococcus aureus and
characterization of methicillin-resistant Staphylococcus aureus isolated from bovine mastitis in Korea. Foodborne Pathog. Dis. 8(2): 231-238.
Nurhayati IS, Martindah. 2015. Pengendalian mastitis subklinis melalui pemberian antibiotik saat periode kering pada sapi perah. Wartazoa. 25(2): 65-74.
Ruegg PL. 2017. A 100-year review: mastitis detection, management, and prevention. J. Dairy Sci. 100(12): 10381-10397.
Rotinsulu DA, Afiff U, Septiriyanti D. 2022. Resistansi Escherichia coli asal feses sapi di wilayah Bogor terhadap antimikrob. ARSHI Vet. Lett. 6(4): 7576.
Saini V, McClure JT, Scholl DT, DeVries TJ, Barkema HW. 2012. Herd-level association between antimicrobial use and antimicrobial resistance in bovine mastitis Staphylococcus aureus isolates on Canadian dairy farms. J. Dairy Sci. 95(4): 1921-1929.
Sashidaran S, Prema B, Yoga LL. 2011. Antimicrobial drug resistance of Staphylococcus aureus in dairy products. Asian Pac. J. Trop. Biomed. 1(2): 130-132.
Tyasningsih W, Ramandinianto SC, Ansharieta R, Witaningrum AM, Permatasari DA, Wardhana DK, Effendi MH, Ugbo EN. 2022. Prevalence and antibiotic resistance of Staphylococcus aureus and Escherichia coli isolated from raw milk in East Java, Indonesia, Vet. World. 15(8): 2021
2028.
Wang K, Cha J, Liu K, Deng J, Yang B, Xu H, Wang J, Zhang L, Gu X, Huang C, Qu W. 2022. The prevalence of bovine mastitis-associated Staphylococcus aureus in China and its antimicrobial resistance rate: A meta-analysis. Front. Vet. Sci. 10(9): 1006676.
Table 1. Antimicrobial resistance patterns of twelve Staphylococcus aureus isolates from cattle milk
|
Isolate ID |
Antimicrobial susceptibility* |
Number of test results* | ||||||||
|
Pen G |
Amp |
Van |
Gen |
Bac |
Cip |
Chlor |
S |
I |
R | |
|
SA01 |
R |
R |
R |
I |
R |
S |
S |
2 |
1 |
4 |
|
SA02 |
R |
R |
S |
S |
S |
S |
S |
5 |
0 |
2 |
|
SA03 |
S |
S |
S |
R |
S |
S |
S |
6 |
0 |
1 |
|
SA04 |
S |
S |
S |
S |
S |
S |
S |
7 |
0 |
0 |
|
SA05 |
R |
R |
R |
S |
R |
S |
S |
3 |
0 |
4 |
|
SA06 |
I |
S |
S |
S |
S |
S |
S |
6 |
1 |
0 |
|
SA07 |
R |
R |
R |
S |
R |
S |
S |
3 |
0 |
4 |
|
SA08 |
R |
R |
R |
R |
R |
R |
R |
0 |
0 |
7 |
|
SA09 |
R |
R |
R |
S |
R |
S |
I |
2 |
1 |
4 |
|
SA10 |
R |
R |
R |
S |
R |
S |
I |
2 |
1 |
4 |
|
SA11 |
S |
S |
S |
S |
S |
S |
I |
6 |
1 |
0 |
|
SA12 |
R |
R |
R |
R |
R |
S |
S |
2 |
0 |
5 |
Note: * Pen G: penicillin G, Amp: ampicillin, Van: vancomycin, Gen: gentamicin, Bac: bacitracin, Cip: ciprofloxacin, Chlor: chloramphenicol, S: susceptible, I: intermediate, R: resistant.

Figure 1. Colonies of Staphylococcus aureus on blood agar plate are gold and have doublezone haemolyses.
Figure 2. Colonies of Staphylococcus aureus are yellow on mannitol salt agar.
Figure 3. Antimicrobial susceptibility test using Kirby-Bauer disk diffusion method.

Figure 4. Antimicrobial susceptibility of Staphylococcus aureus (n = 12) isolated from cattle milk.
331
Discussion and feedback